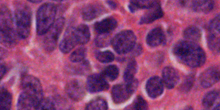

Neuer Therapieansatz gegen Hirntumore bei Kindern
Hirntumorzellen
Hirntumorzellen
Medulloblastome sind die häufigsten bösartigen Hirntumoren im Kindesalter. Der Krebs entsteht aus unreifen embryonalen Zellen und kann noch nicht kausal behandelt werden. Wissenschaftler um Privatdozent Ulrich Schüller vom Zentrum für Neuropathologie und Prionforschung der LMU konnten nun zeigen, dass das regulatorische Protein FoxM1 essentiell für das Wachstum der Tumorzellen ist. Dabei korreliert der FoxM1-Level signifikant mit der Überlebensdauer der Patienten. Deshalb eignet sich das Protein als prognostischer Marker, der in Zukunft Ärzten helfen könnte, die Aggressivität des Tumors einzuschätzen und eine optimale Therapiestrategie für den Patienten zu entwickeln. Und auch für neue Therapien könnte FoxM1 ein Ansatzpunkt sein: Schüller gelang es, FoxM1 mit dem Antibiotikum Siomycin A herunter zu regulieren und so das Wachstum der Tumorzellen zu hemmen. „Sollten sich diese Ergebnisse in weiteren Versuchen im Labor und am lebenden Organismus bestätigen, könnte Siomycin sich als wirksames Medikament entpuppen“, hofft Schüller.
Forschungen der letzten zehn Jahre haben gezeigt, dass Medulloblastome durch die Fehlregulation bestimmter Signalwege verursacht werden. Schüller untersuchte mit seiner Gruppe, ob der Transkriptionsfaktor FoxM1 für das Tumorwachstum eine Rolle spielt und ob er sich als therapeutischer Angriffspunkt für eine kausale Therapie eignet.
Transkriptionsfaktoren regulieren die Umsetzung der im Erbmolekül DNA enthaltenen Informationen in Proteine. Forkhead-Box-Proteine (Fox) sind Transkriptionsfaktoren, die vor allem das Zellwachstum – die sogenannte Proliferation, die Zellspezialisierung und die Lebensdauer von Zellen steuern. FoxM1 aktiviert die Proliferation, indem es die entsprechenden Gene an- und proliferationshemmende Gene abschaltet. Da unkontrollierte Proliferation ein Charakteristikum von Krebszellen ist, ist FoxM1 auch für die Krebsforschung sehr interessant. Für verschiedene Krebsarten - etwa Brustkrebs, Lungenkrebs oder Prostatakrebs – wurden bereits erhöhte FoxM1-Level im erkrankten Gewebe nachgewiesen und gezeigt, dass das Protein für das Tumorwachstum notwendig ist. Schüller konnte mit seinem Team nun nachweisen, dass dies auch für Medulloblastome gilt.
„Ein wichtiges Ergebnis ist auch, dass der FoxM1-Level in Medulloblastomen mit der Überlebensdauer der Patienten korreliert“, sagt Schüller. Da FoxM1 im Labor relativ einfach bestimmbar ist, eignet sich das Molekül daher möglicherweise als prognostischer Marker, der für Therapieentscheidungen eine Rolle spielen könnte: Moderne Behandlungskonzepte kombinieren die chirurgische Tumorentfernung mit Chemo- und Strahlentherapien, die aber schwere Nebenwirkungen haben. Allerdings gibt es sechs Untergruppen von Medulloblastomen, deren Aggressivität und klinische Prognose recht unterschiedlich ist. „Deshalb wäre ein guter prognostischer Marker um die Aggressivität des Tumors einzuschätzen sehr wünschenswert", sagt Schüller - so könnte die Art der Behandlung besser an den Patienten angepasst werden und der Arzt muss nicht möglicherweise mit Kanonen auf Spatzen schießen.
Da FoxM1 für das Wachstum der Tumorzellen essentiell ist, ist das Protein auch ein hoch interessanter Ansatzpunkt für neue Therapien: Mithilfe des Antibiotikums Siomycin A, das gezielt die Produktion von FoxM1 bremst, gelang es Schüller tatsächlich, das Wachstum von Medulloblastomzellen zu hemmen. Damit werden die Ergebnisse anderer Wissenschaftler unterstützt, die die hemmende Wirkung von Siomycin A auf Brustkrebszellen berichteten. Besonders wichtig: Schüllers Untersuchungen zeigten, dass FoxM1 zwar für das Tumorwachstum essentiell ist, im Rahmen der normalen Entwicklung aber offensichtlich durch andere Faktoren kompensiert werden kann - seine Blockade durch Siomycin A also keine negativen Folgen für gesunde Zellen hat. Daher eröffnet Siomycin A möglicherweise zum ersten Mal die Chance, in die Mechanismen der Tumorentstehung einzugreifen und Medulloblastome kausal anzugreifen.Die Arbeiten entstanden im Rahmen der von der Deutschen Krebshilfe geförderten Max-Eder-Nachwuchsgruppe „Pädiatrische Neuroonkologie", die von Ulrich Schüller geleitet wird.
Weitere Informationen
Zur Deutschen Krebshilfe e. V.


